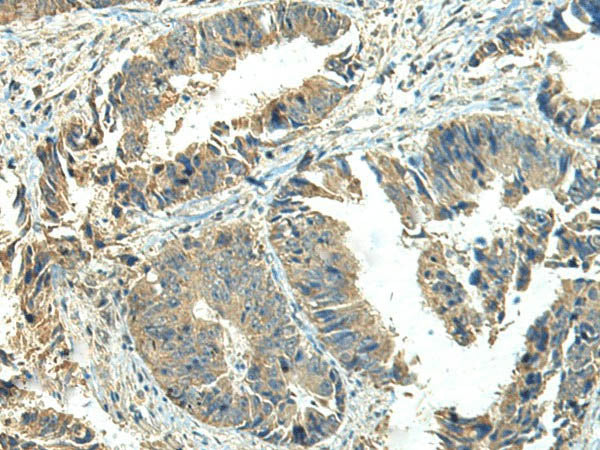
NPVF Polyclonal Antibody

NPVF Polyclonal Antibody
Regular price
$ 559.95
Couldn't load pickup availability

Still have questions? Ask our experts!
NPVF Polyclonal Antibody
| SKU # | E-AB-19861 |
| Reactivity | Human |
| Host | Rabbit |
| Applications | IHC |
Product Details
| Isotype | IgG |
| Host | Rabbit |
| Reactivity | Human |
| Applications | IHC |
| Clonality | Polyclonal |
| Immunogen | Synthetic peptide of human NPVF |
| Abbre | NPVF |
| Synonyms | C7orf9, NPVF, Neuropeptide NPSF, Neuropeptide NPVF, Neuropeptide RFRP-1, Neuropeptide RFRP-2, Neuropeptide RFRP-3, Neuropeptide VF, RFRP |
| Swissprot | |
| Cellular Localization | Secreted. |
| Concentration | 1.98 mg/mL |
| Buffer | Phosphate buffered solution, pH 7.4, containing 0.05% stabilizer and 50% glycerol. |
| Purification Method | Antigen affinity purification |
| Research Areas | Cell Biology, Signal transduction |
| Conjugation | Unconjugated |
| Storage | Store at -20°C Valid for 12 months. Avoid freeze / thaw cycles. |
| Shipping | The product is shipped with ice pack,upon receipt,store it immediately at the temperature recommended. |
Related Reagents
| Applications | Recommended Dilution |
| IHC | 1:50-1:300 |
Background
Neuropeptide RFRP-1 acts as a potent negative regulator of gonadotropin synthesis and secretion. Neuropeptides NPSF and NPVF efficiently inhibit forskolin-induced production of cAMP, but RFRP-2 shows no inhibitory activity. Neuropeptide RFRP-1 induces secretion of prolactin in rats. Neuropeptide NPVF blocks morphine-induced analgesia.